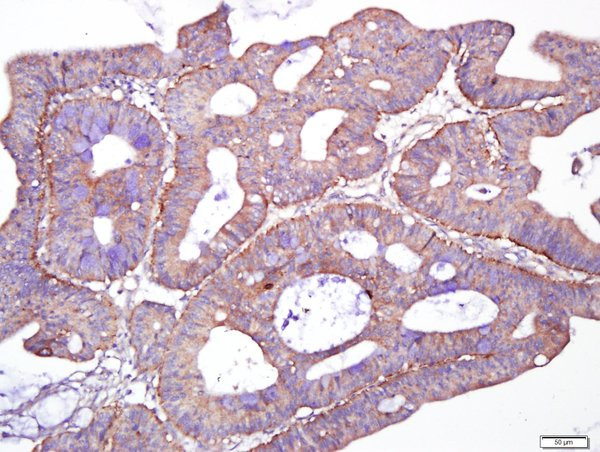
Giantin/GOLGB1 Antibody in Immunohistochemistry (Paraffin) (IHC (P))

Search
Bioss
Giantin/GOLGB1 Polyclonal Antibody
{{$productOrderCtrl.translations['antibody.pdp.commerceCard.promotion.promotions']}}
{{$productOrderCtrl.translations['antibody.pdp.commerceCard.promotion.viewpromo']}}
{{$productOrderCtrl.translations['antibody.pdp.commerceCard.promotion.promocode']}}: {{promo.promoCode}} {{promo.promoTitle}} {{promo.promoDescription}}. {{$productOrderCtrl.translations['antibody.pdp.commerceCard.promotion.learnmore']}}
图: 1 / 4
Giantin/GOLGB1 Antibody (BS-13356R) in IHC (P)




产品信息
BS-13356R
种属反应
宿主/亚型
分类
类型
抗原
偶联物
形式
浓度
纯化类型
保存液
内含物
保存条件
运输条件
靶标信息
Golgin subfamily B member 1 (GOLGB1) is a single pass type I membrane protein located in the golgi apparatus membrane. GOLGB1 may participate in forming intercisternal cross-bridges of the Golgi complex.
仅用于科研。不用于诊断过程。未经明确授权不得转售。
篇参考文献 (0)
生物信息学
蛋白别名: 372 kDa Golgi complex-associated protein; GCP372; Giantin; golgi autoantigen, golgin subfamily b, macrogolgin (with transmembrane signal), 1; golgi autoantigen, golgin subfamily b, macrogolgin 1; golgi integral membrane protein 1; golgi-associated protein GCP360; golgin B1, golgi integral membrane protein; Golgin subfamily B member 1; Macrogolgin
基因别名: 4930428L02Rik; GCP; 628101; 6330407A06Rik; AU042952; C130074L01Rik; F730017E11Rik; GCP372; Gm6840; GOLGB1; GOLIM1; mKIAA4151
UniProt ID: (Human) Q14789
Entrez Gene ID: (Human) 2804, (Mouse) 224139, (Rat) 192243